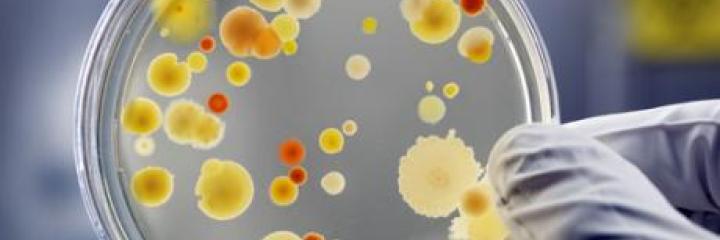
Air Purification Technology

Addressing Global Challenges
We are committd to tackling the greatest global challenges of our time with multidisciplinary solutions.
Aging Global Population
Our clinical research and health technology expertise is dedicated to creating new medicines and therapeutics, addressing age-related and emerging non-communicable diseases.

Alzheimer’s
Our scientists race against time to conduct breakthrough research that can help us advance our understanding of how the brain functions, providing important clues for developing innovative therapies to curb Alzheimer’s disease.

Parkinson’s and ALS
The discoveries of the mechanism of axon regeneration and the role of a new protein in delaying the degradation of damaged nerves offer hope to patients with spinal cord injuries such as Parkinson’s disease and Amyotrophic Lateral Sclerosis (ALS).

Sound Advance in Hearing Aids
A faculty-student team has developed a cost-effective intelligent hearing aid, which allows the elderly and the hearing-impaired to selectively reduce annoying background noise and costs only one-tenth the price of similar products in the market.

Smart Wheelchairs
An autonomous all-terrain wheelchair equipped with sensors is designed for the elderly to navigate in complex environments and avoid obstacles based on the surrounding 3D information.

Healthcare Operations
We conduct operations and decision analytics research in the hope of improving healthcare operational efficiency across the elderly care continuum, resulting in better care for the elderly and a more efficient workflow for care providers.
Chronic Diseases Control
We are constantly researching and developing revolutionary approaches to combating chronic illnesses, halting epidemics and boosting people’s mental health.

Antibiotics against Superbugs
A marine life research team discovered 7,300 new ocean species and a new type of bacteria that have the potential for new antibiotics development, providing new hope to millions of patients suffering from rare diseases.

Brain Cancer
A drug molecule co-identified by our research team offers hope of longer life to chemo-resistant patients of a rare and deadly type of brain cancer – secondary glioblastoma.

HIV
An interdisciplinary research group has mapped out the fitness landscape of a crucial protein in HIV by employing a computational framework, potentially paving the way for the design of a vaccine that may force the deadly virus to mutate into forms that destroy it.

Lung Disease
We are developing an innovative medicine ATYR1923, a potential therapeutic for patients suffering from interstitial lung diseases with no known cure, through clinical development.

Mental Disorders
The unveiling of the fundamental mechanism that causes schizophrenia and other serious psychiatric conditions may potentially lead to the development of new treatments and drugs for mental disorders.
Natural Resources Conservation
Through innovative conservation technologies and policies, we are reshaping standards in water and air quality, renewable energy, and marine sustainability. In doing so, we are actively advancing the SDGs of clean water, energy, climate action, and life below water.

E-Fuel Energy Storage System
Our scientist leads a large-scale research project to develop an energy storage system that incorporates electrically rechargeable liquid fuels known as e-fuels. It helps to address existing challenges preventing the widespread use of renewable energy due to the intermittent nature of solar and wind energy.

Diagnosing Our Oceans
A HKUST multidisciplinary research team investigates the driving forces of the increasing eutrophication and hypoxia in Hong Kong coastal waters, contributing toward government policy by providing a scientifically-based strategy for stabilizing or reversing the problem for a more sustainable marine environment.

Remodeling Central Chiller Plant
We have upgraded our central chiller plant, which adopts a seawater-cooled central chilling technology into a district cooling system, to provide air-conditioning to expanded infrastructure, helping to save millions of dollars and over 20 percent of energy consumption.

SANI Wastewater Treatment Project
Our sewage treatment technology SANI - Sulphate reduction, Autotrophic denitrification and Nitrification Integrated Process - minimizes the adverse environmental impact of sewage treatment by eliminating 90% of sewage sludge production, cutting down sewage treatment cost by 50% and also greenhouse-gas emission by 35%.

Vessel Emission Sensor
A new sensor system designed to detect pollutants from vessels is capable of measuring real-time vessel fuel Sulphur content in 2 minutes with an accuracy rate of over 90%. The senor-equipped drones will help enforce the tightened Air Pollution Control (Fuel for Vessels) Regulation more effectively.
Sustainable Urban Living
Our multidisciplinary smart city solutions are designed to lower per capita environmental impact, mitigate climate change-related damage, and cultivate safer, more resilient cities that reflect the SDG target of more sustainable urban communities.

AI-powered Weather Prediction System
An international and multidisciplinary research team has developed a real-time AI-powered extreme weather and landslide warning system to mitigate the risks and damage of landslides in Hong Kong, setting a benchmark for landslide-prone regions around the world.
Air Purification Technology
Our researchers have developed an air purification system that removes 99% of airborne bacteria and viruses, including influenza (H1N1, H3N2), EV71 and deadly MERS-Cov. The technology can be incorporated into a wide range of products and applied to areas such as the purification of sewage discharge.

PRAISE-HK Air Quality App
The newly-launched mobile app provides real-time air quality and health risk information and 48-hour forecasts down to street level, helping users reduce their exposure to outdoor air pollutants.

Smart Urban Water Supply Systems
The aging urban water supply systems (UWSS) are challenged by urban growth and climate change worldwide. Our theme-based research program aims to develop pioneering methodologies that will assist the design, operation, monitoring, and diagnostic repair of UWSS, potentially benefiting 3 billion people globally.

Sustainable Smart Campus as a Living Lab
This new initiative transforms our campus into a testing ground for learning, experimenting, and advancing innovative ideas to address real-life sustainability challenges. Multiple smart and cross-disciplinary projects developed by our faculty, staff, students, and alumni will contribute to building Hong Kong into a world-class sustainable and smart city.

Promoting Carbon Neutrality
In pursuit of achieving carbon neutrality and upholding the UN Sustainable Development Goals, HKUST proactively fosters partnerships with a wide spectrum of stakeholders to promote knowledge exchange and collaboration. With the joint effort and commitments, HKUST strives to work closely together with our engaged partners to secure a sustainable future.
Technological Advancement and Inventions
Championing scientific and tech discovery, we tirelessly propel the SDG's vision of fostering resilient infrastructures and inclusive, sustainable industrialization. Our pursuit of transformative innovations significantly contributes to the sustainable growth of the economy, society, and environment globally.

Drone Technology
Founded and incubated by an alumnus and a faculty member, DJI holds more than 75% of the civilian drone market share and develops drones that can handle complex terrains via pioneering motion control and robotic perception technologies. The company has created more than 5,000 jobs and offered scholarships to foster robotics research.

Solid Elastic Metamaterial
Our physics’ research team created a solid elastic metamaterial that can filter transverse waves within a certain range of frequencies. As transverse waves can lead to destructive horizontal shaking during earthquakes, this filtering property may provide an alternative earthquake-proofing solution.

FinTech Development
A multidisciplinary FinTech research project is building a roadmap for transforming Hong Kong into a global FinTech hub through the delivery of policy recommendations, scholarly contributions, and industrial impacts.

LED Lighting
Our expert in semiconductor materials and devices works to advance LED-based lighting technologies that will open up new applications, improve reliability and lower manufacturing costs through the integration of LEDs on silicon wafers.

Liquid Crystal Display
A research team from HKUST State Key Laboratory of Advanced Displays and Optoelectronics Technologies has developed a liquid-crystal display that increases energy efficiency by three to five times while image resolution was enhanced by three times at a lower cost.

Quantum Communication
A research team has found a way to boost the efficiency of photonic quantum memories to over 85% with fidelity of over 99%, pushing quantum computation a step closer to reality.

Smart Green Wall Panels
An engineering research team was granted a research fund to design and develop smart green wall panels which will reduce the energy consumed in space conditioning, providing a smart solution for building thermal management.
Twenty-First Century Education
By arming learners of all ages and walks of life with crucial technical and soft skills, we facilitate the creation of sustainable solutions for global issues, striving towards the SDG of ensuring quality education and promoting lifelong learning opportunities for all.

E-learning Behaviour
Our engineering research team has developed the first visual-based analytical system for Massive Open Online Courses (MOOC) videos, which provides interactive, in-depth, and user-friendly analysis of e-learning behavior, promising improvement in teaching quality and more demand-focused MOOC programs.

Entrepreneurship Mentorship
We connect our students to a vast network of mentors who are serial entrepreneurs, VC or alumni. They offer startup advice and guidance on vision and mission, helping student entrepreneurs turn their innovative business ideas into reality that can make a difference in the world.

ICRC Traineeship Program
The one-year International Committee of the Red Cross (ICRC) traineeship program, an experiential learning opportunity exclusively for HKUST students, allows the selected candidate to gain a deeper understanding of humanitarian work and nurture a global vision for sustainable development.

Intimacy of Creativity
The first-of-its-kind program in creative arts and music education. Renowned global composers and performers are invited to participate in open discussions, lectures, and concerts, providing our students with a unique learning experience to be developed into innovative and imaginative thinkers.

SIGHT for Healthcare Innovation
The Student Innovation for Global Health Technology (SIGHT) program challenges students to create and implement innovative solutions against a broad range of healthcare problems for resource-limited communities through coursework, team projects, and overseas study trips.

STEM Education
A one-stop STEM learning hub to spark junior high students’ inquisitiveness and inspire young learners to solve everyday problems with a scientific mind. The platform provides a wide variety of STEM resources accessible to teachers, students, and the general public.

Underwater Robot Competition
Organized by the Center for Global & Community Engagement, the competition invites students from mainstream schools and those with special educational needs and physical disabilities, and ethnic minority students to design and build their own underwater robot to complete different underwater missions.
Covid-19
Facing a global health crisis that threatened people of all ages and backgrounds, we swiftly spearheaded pioneering solutions that aligned with the SDG of promoting global health and well-being for humanity.

Prevention
To halt the community spread of the virus, an automated geo-fencing technology has been adopted by the Hong Kong government to monitor and track home confines under quarantine in addition to a smart fever screening system being deployed in the city’s border control points and public venues such as schools and a public library.

Mitigation
Measures put in place to keep the outbreak under control include the deployment of autonomous vehicles that deliver groceries in mainland cities to minimize human contact, and the application of a new antimicrobial formula that can kill a wide spectrum of viruses and bacteria in multiple venues across Hong Kong.

Treatment
To make early diagnosis and treatment possible, our researchers have come up with a portable detection device that can detect the virus in just 40 minutes, and developed a COVIDep platform to provide immune target recommendations to scientists and CAiRE-COVID, a machine learning based-system to facilitate the medical community to find answers to COVID-related enquiries, in the hope of finding a cure.

Policy
Enhancing public health emergency preparedness is key to navigating health threats.
Our public policy experts have shared their insights into scaling up the authorities’ response capacities for disease control through an online seminar co-organized with another university and a research paper published worldwide.

Education
The University is adopting a real-time interactive online teaching mode for all classes for the entire Fall Term 2020/21 in light of the evolving COVID-19 situation in Hong Kong. Multiple contingency plans are also in place to better respond to sudden changes in a timely manner to uphold our commitment to quality education.

Outreach Service
To protect Hong Kong’s most vulnerable groups against the coronavirus, HKUST Connect initiated a donation campaign to collect protective supplies and disinfectants, with almost 5,000 pieces of masks and over 2,000 bottles of hand sanitizers distributed to a few NGOs.

Keeping Our Community Updated
Ensuring the health and safety of our students, staff, and alumni remains our priority. A COVID-19 Info@HKUST online platform has therefore been established to provide the University community with all the related information including health advice, university arrangements, and precautionary measures.








